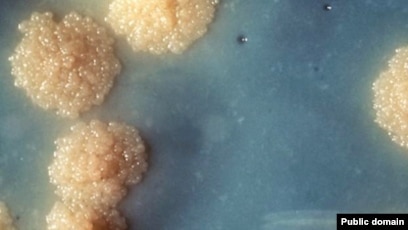

Фото Вакцины Под Микроскопом

💣 👉🏻👉🏻👉🏻 ИНФОРМАЦИЯ ДОСТУПНА ЗДЕСЬ! КЛИКАЙ 👈🏻👈🏻👈🏻
Существа COVID вакцины: под микроскопом : leonard17 — ЖЖ
Вакцина Pfizer/BioNTech под микроскопом - YouTube
Содержимое ковидных вакцин: еще два доктора рассказывают . . .
Бездоказательно: «Фото вакцины под микроскопом . . .» - StopFake!
Электронная микроскопия выявляет присутствие оксида графена . . .
ВАКЦИНА ПОД МИКРОСКОПОМ . . . Не делайте прививки от . . .
Микрочипы в вакцинах? Анализ крови даёт удивительные . . .
Как устроена вакцина Спутник-5 и как она вызывает . . . | Пикабу
Вакцина Спутник V Под Микроскопом . | Апокалипсис Здесь . . .
Графен . Отсутствие мРНК (Генной терапии) в вакцине Pfizer
Наташа Королева Фото Пляж
Светлане Цветы Картинки
Картинки Домики Из Сладкого
—- Существа COVID вакцины были замечены . под микроскопом доктора Кэрри Мадей, смелой и очень осведомленной женщины, которая уже некоторое время подчеркивает истинную повестку дня трансгуманизма, стоящую за мошенничеством с COVID .
Вакцина от Pfizer/Biontech помещена под стандартный микроскоп . То, что происходит с ней за эти 12 минут, очень интересно и вызывает множество вопросов .
Содержимое ковидных вакцин начинает выявляться различными независимыми врачами по Содержимое ковидных вакцин: д-р Зандре Бота . Доктор Зандре Бота из Южной Африки Кровь вакцинированного COVID пациента под микроскопом показывает деформированные . . .
В соцсетях распространяют снимки, утверждая, что на них вакцина против COVID-19 под микроскопом . Анализ крови якобы показал наличие в ней руло - стопок из эристроцитов, а фото вакцины под микроскопом - наличие неких неопознанных частиц .
Фазированная контрастная микроскопия темного и светлого поля, просвечивающая и сканирующая электронная микроскопия и энергодисперсионная рентгеновская спектроскопия раскрывают ингредиенты вакцин Cov-19!
Не делайте прививки от Ковида! Документы на отказ армейцев и учителей . (ВИДЕО) . В одном нет никаких сомнений . Путинский Спутник-V и все остальные вакцины от Ковида - не лучше . Они все имеют один и тот же базовый состав Билл Гейтса, включающий в себя отравляющие . . .
Дискуссии о вакцинах и вакцинации от COVID-19 не затухают, а, наоборот, становятся всё более горячими . Даже серьёзные медики сомневаются, что у них есть полное представление о составе тех препаратов, которыми делаются прививки . Что же там находится на самом деле?
Официальной информации по вакцине достаточно мало, кроме того, что она векторная и двухкомпонетная, что для большинства людей мало что проясняет . Для начала разберёмся что же такое вектор АД он же Ad он же AAV вектором является аденовирус (или . . .
сравнению с бактерией, бактерия - одна клетка, личинка шистосомы - церкарий имеет размер 0,3-1 мм а стрептококк - 0,5-1 мкм - разница в 1000 раз в размерах . можно ли вколоть личинки размерами до 1 мм через иглу шприца? фото личинки шистосомы посмотрите - церкарий . . .
(слева, вакцина Pfizer; р . Графен) . Испанские исследователи поместили вакцину Pfizer под электронный микроскоп и обнаружили, что она содержит 99% оксида графена и почти ничего больше . Практически НЕТ доказательств того, что эта "вакцина" является генной терапией .
О Смерти Хабиба Нурмагомедова Последние Новости Фото
Джетта 2022 Фото
Комоды В Тюмени Фото И Цены
Стрижка Теннис Мужская Фото Вид
Фото Девушек Пухлых На Аву
Овощной Пирог Фото
Каркасные Бассейны В Теплице Фото
Ночью Голая Баба На Кровати Фото
Хендай 2016 Фото
Эротические Картинки Девушек На Рабочем Месте
Интеллект Фото Челябинск Интернет Магазин
Найти Паука По Фотографии
Lola Bunny Фото У Храма Без Цензуры
Кинотеатр Художественный Фото Залов
Фото Приколы За Рулем
Шарлотка С Безе Сверху Рецепт С Фото
С Днем Рождения Никита Картинки Красивые
Добавить Две Фотографии В Инстаграм
Домашние Фото Дам 50
Кура Орпингтон Фото
Частное Порно Фото Женщин В Теле
Картинки Разбитого Сердца На Обои
Картинки Купить Диван
С Картинки Убрать Нижнее Белье Онлайн
Сюжетные Картинки Зима
Боги Египта Картинки 5 Класс
Спортивный Массаж Фото
Исторические Фотографии Сайт
Солнечная Система Детские Картинки
Бесплатное Фото Голых Девушек Подростков
Как Изменить Фото Профиля На Госуслугах
Нарисуй Фото Коров
Актеры Без Макияжа Фото
Томат Лирика Описание Сорта Фото
Старые Фотографии Харькова
Просто Дурак Картинки
Купить Дачу Недорого Цена Фото
Творожные Печенье Поцелуйчики Рецепт С Фото Пошагово
Домашнее Фото Зрелых Сисястых Женщин
Утки Маленькие Фото
Творог Фото На Белом Фоне
Спасательный Круг Картинка
Фото Рисунков Милых Котиков
Ангелина Вовк Биография Возраст Дети Фото
Порно Фото Несовершеннолетних Анал
Пьеса М Мусоргского Картинки С Выставки
Картинки Добрый Осенний День Красивые С Пожеланиями
Фартуки Для Кухни Фото Современные Идеи Каталог
Дети Лады Дэнс Фото Сейчас
Кусает Попу Фото
Картинки Мультяшных Мышат
Голые В Окне Фото
Немецкая Откровенное Фото
Фото Верхней Губы Гиалуроновой Кислотой
Фото Мужика С Бородой
С Днем Рождения Любашка Картинки С Пожеланиями
Фото Ванны Со Стеновыми Панелями
Спокойного Утра Картинки Прикольные
Купить Умывальник В Калачинске Цена Фото
Фотографии Пола Уокера
Сон Фотография Любимого
Лучшая Картинка На Рабочий Стол 1280х1024
Клим Шипенко И Ксения Буравская Фото
Хуанита Санчес Горячие Фото Актриса
Артисты Сериала Не Родись Красивой Фото
Картинки Халка Из Мстителей Война Бесконечности
Картинка С Пожеланием Счастья Скачать Бесплатно
Рим Фото На Рабочий Стол
Ксения Корнева Интимные Фото
Игорь Ивлев Фото
Плавбаза Всеволод Сибирцев Фото Внутри И Снаружи
Ногти Серые Фото Новинки
Александр Феклистов С Женой И Детьми Фото
Тигр Весной Фото
Фото Длинных Ровных Волос
Смена Молочных Зубов У Детей Фото
Кабачки С Овощами Рецепты С Фото
Картинки Германии В Виде Человека
Девушки В Красивых Длинных Платьях Картинки
Салтыковские Бани Калуга Цена Фото
Фото Жена Друга Русское
Лансер 10 Фото Цена
Поменять Формат Фото С Heic На Jpg
Фото Охотничьих Ножей Ручной
Закхаймские Ворота Калининград Фото
Птицы Поволжья Фото С Названиями
Девушки Трусиках Фото Вид Сзади
Блондинка Фигура Фото
Картинка Храни Людей Которых Я
Романтические Картинки Пар
Салтыкова Ирина Фото В Журнале Максим
Бараньи Потроха Рецепты Приготовления С Фото
Фото Банки Джин Тоника
Саша Колесников Фото
Части Растений Картинки Схема 1 Класс Раскраска
Пазлы По Фото На Заказ Новосибирск
Круглые Дома В Нидерландах Фото Внутри
Николай Погодин Актер Фото
Пушкин Пишет Фото
Скачать Картинки Разные Красивые С Надписями
Фото Вакцины Под Микроскопом






































































.jpg)

_d_850.jpg)




